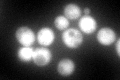
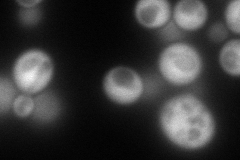
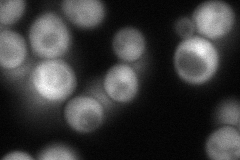
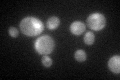

View description
Isopentenyl diphosphate:dimethylallyl diphosphate isomerase (IPP isomerase), catalyzes an essential activation step in the isoprenoid biosynthetic pathway; required for viability
Localization:
Intensity:
Fold change:
Significance:
-
C’ GFP library in SD
nucleus:cytosol106.41 -
N' NOP1pr-GFP in SD
cytosol202.255 -
N' TEF2pr-mCherry in SD

cytosol241.095 -
N' NATIVEpr-GFP in SD
cytosol101.344 -
N' TEF2pr-VC and Cyto-VN in SD

cytosol66.5092 -
C’ GFP library in SD+DTT

nucleus.cytosol98.220.92No -
C’ GFP library in SD+H2O2

nucleus.cytosol107.461No -
C’ GFP library in Starvation Media
nucleus,cytosol87.150.81No -
C’ GFP library on the background of Pup2-DaMP

nucleus:cytosol -
C’ GFP library on the background of CCT mutant

nucleus:cytosol108.5031.01959No
